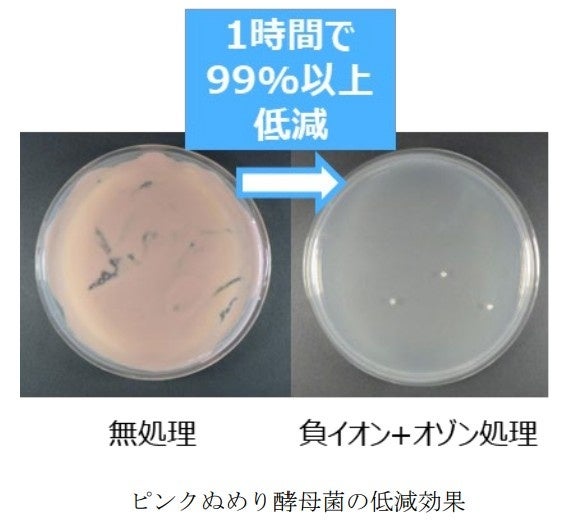
三菱電機、オゾンと負イオンの相乗効果で除菌・脱臭を強化 - 画像5

世界初となるメカニズム解明
三菱電機株式会社は、国立大学法人東京科学大学(Science Tokyo)生命理工学院の蒲池教授らと共同で、負イオンを併用することでオゾンの酸化作用を向上させるメカニズムを世界で初めて解明したとのことです。

このメカニズムは、負イオンが水分に溶解すると、負イオン由来の硝酸系成分によりpHが低下するため、水分中のオゾンの酸化作用が高まるというものです。これにより、低濃度オゾンでもウイルスや菌などに対し強力な低減効果を発揮することが明らかになりました。
今回の研究では、オゾン濃度50ppb以下で、これまで報告されていた特定のウイルスに加え、菌や臭気などに対する低減効果も確認されています。
Ms.ガジェット背景と課題
近年、建物の高気密・高断熱化が進み、換気が不十分な屋内では衛生環境が悪化する懸念が高まっています。従来、オゾンの酸化作用を利用して屋内の衛生環境を保ってきましたが、オゾン単体では効果の持続性や安定性に課題がありました。

オゾンがウイルスや菌に対して低減効果を示すことは知られていましたが、負イオンを併用した場合に効果が増加することや、pHによって効果が変化することについて、負イオンの化学種やpH制御効果は明確ではありませんでした。
今回の共同研究により、三菱電機が培ってきた評価技術とScience Tokyoの分析技術を組み合わせ、負イオンが水分中でpHを制御するプロセスを明確化し、メカニズム解明に至りました。
Ms.ガジェット開発の特長
1.負イオンの併用によるオゾン酸化作用向上メカニズムの解明
研究チームは、放電活性種の多角的な検証から、負イオンとオゾン照射後の水分に含まれる硝酸系イオンがpH低下を引き起こすことを解明しました。放電活性種とは、電気的な放電によって生じる化学的に活発な分子や原子のことです。

その結果、大気中の低いオゾン濃度でも、pHが低下することで水分中のオゾンの溶存濃度が1.5倍となり、オゾンの酸化作用が向上することが確認されました。
2.低いオゾン濃度での除菌・脱臭効果
三菱電機は、負イオンによる水分pH制御によって低濃度オゾンでも酸化作用を効率的に高めるデバイスを開発しました。このデバイスにより、50ppb以下の低いオゾン濃度でも高い除菌・脱臭効果を実現しています。
実験では、試験片に付着した大腸菌や水回りのピンクぬめり酵母菌を1時間で99%低減、試験布に付着した汗臭や生乾き臭を1時間で臭気強度1以上低下させる効果が確認されました(臭気強度1は、6段階評価で90%以上の臭気低下に相当)。
Ms.ガジェット今後の展望
三菱電機は、今後もこの技術を応用し、学校、病院、オフィスなどの公共施設や、リビング、キッチン、浴室などの生活空間、さらには自動車や公共交通機関などの移動空間におけるウイルスや菌、臭気の発生を抑制するデバイスの開発を目指すとしています。
デバイスの小型化や高効率化を図り、各空間の特性に合わせた最適な除菌・脱臭ソリューションを提供することで、安心・安全で快適な社会の実現に貢献していく方針です。
本開発成果の詳細は、12月15日から20日までハワイで開催される国際会議「Pacifichem 2025」で発表予定です。
Ms.ガジェットCATEGORY_ID: 14

最後までお読みいただきありがとうございました!
- 本記事の評価は当サイト独自のものです。
- 特段の表示が無い限り、商品の価格や情報などは記事執筆時点での情報です。
- この情報が誤っていても当サイトでは一切の責任を負いかねますのでご了承ください。
- 当サイトに記載された商品・サービス名は各社の商標です。
- 本記事で使用している画像は、メディアユーザーとしてPR TIMESより提供されたプレスリリース素材を利用しています。

